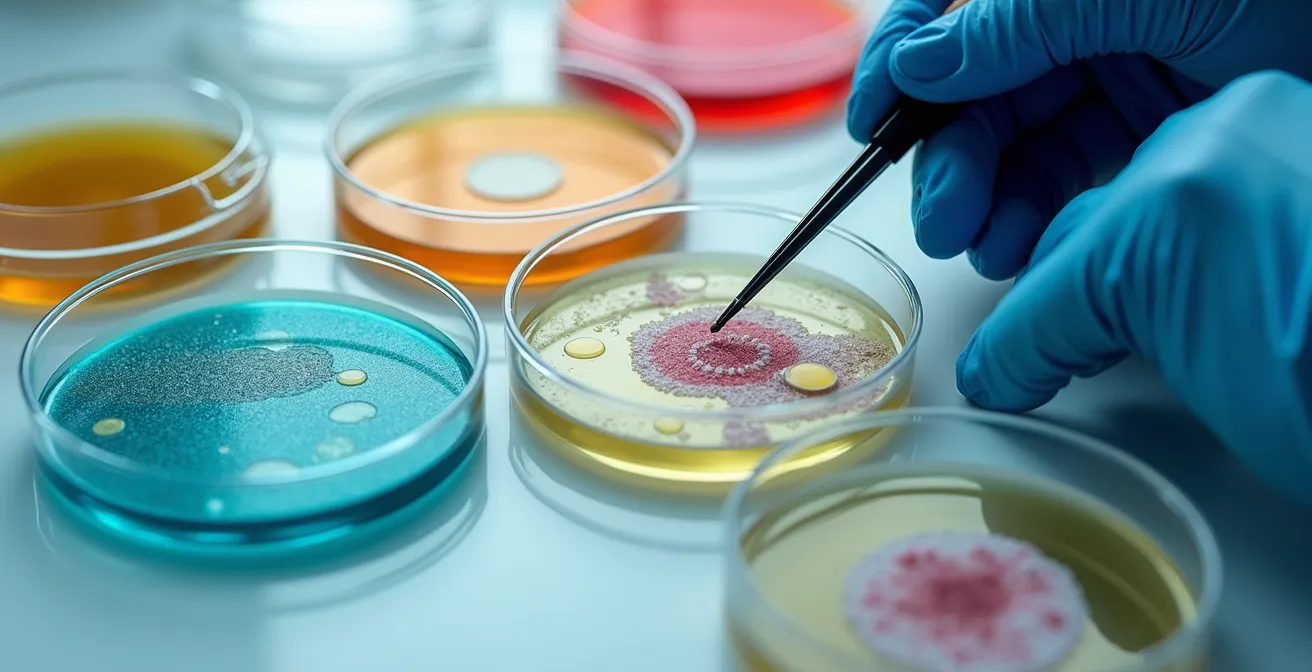
Macro view of laboratory culture plates showing bacterial growth patterns for antibiotic sensitivity testing

Contrary to common belief, escalating your pet’s chronic care to a specialist isn’t a critique of your general vet, but a necessary step when the system of general practice is no longer sufficient.
- General practice is designed for primary care, not the deep investigation required for complex, recurring conditions.
- True “standard of care” for many chronic illnesses inherently involves specialist-level diagnostics and expertise that a GP is not trained or equipped to provide.
Recommendation: Stop the cycle of repeat visits and failed treatments. Use this guide to identify the specific red flags that indicate it’s time to advocate for a referral to a board-certified specialist.
You’ve been back to the clinic three, maybe four times for the same issue. A persistent skin infection, a recurring urinary problem, a limp that never fully resolves. Each time, you leave with another course of antibiotics or a pain medication, a flicker of hope, and a lighter wallet. Yet, the problem returns. This cycle of frustration is exhausting, and it’s easy to start questioning your veterinarian’s competence. But what if the problem isn’t your vet, but the very system they operate within?
Most pet owners believe the choice between a general practitioner (GP) and a specialist is simply about “complexity” or cost. The reality is far more nuanced. It’s about understanding the fundamental, systemic differences in training, diagnostic philosophy, and even legal frameworks that define their roles. Your GP is the frontline of animal healthcare, expertly equipped to handle the vast majority of issues, from vaccinations to routine illnesses. Their training is broad, by necessity.
However, when an issue becomes chronic or defies initial treatments, you enter a territory where that broad approach becomes a liability. This is where “diagnostic inertia”—the tendency to stick with an initial diagnosis despite poor outcomes—sets in. The solution isn’t another round of the same treatment; it’s a paradigm shift in the diagnostic approach. This article will deconstruct the common scenarios where a GP’s ‘best effort’ is structurally insufficient and empower you to recognize when escalating to a board-certified specialist is not just an option, but the most logical and often most cost-effective path to a real solution.
We will dissect the dangerous myths surrounding common procedures, decode the financial language of treatment, and reveal the systemic blind spots in veterinary training that directly impact your pet’s care. By understanding these systems, you can transform from a frustrated client into an empowered advocate for your pet’s health.
Summary: Standard Care or Specialist: Who to Trust for Chronic Issues?
- Why “Anesthesia-Free” Dentistry Is a Dangerous Cosmetic Scam?
- How to Decipher a Vet’s Treatment Estimate Without Panic?
- Surgery or Conservative Management: Deciding for a Torn CCL
- The Dosing Mistake That Makes Antibiotics Fail in 50% of Cases
- Timeline for Spay Recovery: What to Expect Day by Day?
- Why General Vets Receive Less Than 20 Hours of Nutrition Training?
- Why “Replacement Value” Limits Damages in Vet Lawsuits?
- Kidney Failure: The Silent Symptoms Most Owners Miss Until Stage 3
Why “Anesthesia-Free” Dentistry Is a Dangerous Cosmetic Scam?
One of the most pervasive and dangerous myths that preys on owner fears is the concept of “anesthesia-free” dentistry. Marketed as a safer, cheaper alternative, it’s nothing more than a cosmetic procedure that provides a false sense of security while allowing periodontal disease to fester below the gumline. The visible part of the tooth, the crown, may look clean, but the real damage—infection, bone loss, and pain—occurs in areas that are impossible to see, let alone treat, on a conscious animal.
The American Veterinary Dental College is unequivocal on this matter: their research shows that 0% of periodontal disease below the gumline can be treated without anesthesia. Attempting to do so is not just ineffective; it’s stressful and painful for the pet. A proper dental cleaning and assessment requires probing under the gums, taking X-rays to evaluate tooth roots, and scaling and polishing surfaces that a conscious animal would never tolerate. Anesthesia is not a convenience; it is the cornerstone of safe, effective, and humane dental care.
The fear of anesthesia is understandable, but it is largely based on outdated information. Modern anesthetic protocols, especially those overseen by specialists or in high-quality general practices, are incredibly safe. The risk is minimized through a multi-layered approach to patient safety that transforms the procedure from a source of anxiety into a well-controlled medical event.
Your Action Plan: The Modern Anesthetic Safety Protocol Checklist
- Pre-anesthetic Bloodwork: Insist on blood tests to assess organ function (especially kidney and liver) to ensure your pet can safely process the anesthetic drugs.
- Dedicated Anesthetic Technician: Confirm that a trained technician or veterinarian will be dedicated solely to monitoring your pet throughout the entire procedure. This is not a job to be done “on the side.”
- IV Catheter Placement: An intravenous catheter is non-negotiable. It provides instant access for administering drugs in an emergency and for providing fluids to support blood pressure.
- Endotracheal Intubation: The placement of a breathing tube is essential to protect the airway from bacteria-laden water used during the cleaning and to ensure the patient receives oxygen and anesthetic gas effectively.
- Continuous Vital Signs Monitoring: Your pet’s heart rate, respiratory rate, blood oxygen levels, and blood pressure should be monitored continuously from induction to recovery.
- Body Temperature Support: Anesthetized patients lose body heat. Ensure the clinic uses warming devices like forced-air blankets or circulating water pads to maintain a stable body temperature.
By understanding what constitutes a safe anesthetic event, you can confidently reject the dangerous scam of anesthesia-free cleanings and advocate for the true standard of care your pet deserves. This is the first step in differentiating between superficial treatments and genuine medical solutions.
How to Decipher a Vet’s Treatment Estimate Without Panic?
The moment a multi-page treatment estimate is placed in your hands can be overwhelming. The string of medical terms and high costs often induces a state of panic, making rational decision-making difficult. The key to navigating this moment is to stop seeing the estimate as a simple bill and start seeing it as a proposal of care philosophy. The numbers are not arbitrary; they reflect a specific level of medical intervention, and you have a right to understand what you are paying for.

Often, a single condition can be approached in several ways, ranging from basic stabilization to the most advanced care available. A good veterinarian, particularly a specialist, will be able to discuss these options with you. This is not about “upselling” but about transparently presenting the different paths and their associated prognoses. Your role is to ask questions that help you understand which tier of care is being proposed and why. Is this the “gold standard” or a more conservative approach? What are the expected outcomes for each?
Understanding these tiers is crucial for making an informed choice that aligns with your budget, your goals for your pet, and the specific medical situation. The following table breaks down the common philosophies of care you might encounter.
| Care Tier | Description | Typical Cost Range | When to Choose |
|---|---|---|---|
| Tier 1: Essential/Stabilization | Minimum required treatment to stabilize condition | $ | Limited budget, elderly pets, palliative care |
| Tier 2: Standard of Care | Comprehensive treatment meeting professional standards | $$ | Most chronic conditions, good prognosis cases |
| Tier 3: Gold Standard/Specialist | Advanced specialist care with cutting-edge options | $$$ | Complex cases, best possible outcomes desired |
By framing the discussion around these tiers, you shift the conversation from “Why is this so expensive?” to “What level of care are we aiming for, and what are the alternatives?” This empowers you to be an active participant in the decision-making process, ensuring the chosen path reflects a true partnership between you and your veterinary team.
Surgery or Conservative Management: Deciding for a Torn CCL
The diagnosis of a torn Cranial Cruciate Ligament (CCL), the equivalent of a human’s ACL, is a classic crossroads for a pet owner. It presents a stark choice: major orthopedic surgery or a non-surgical path known as conservative management. For many GPs, especially with smaller dogs, conservative management (rest, anti-inflammatories, weight management) is often presented as a viable first-line option. For a specialist, however, the decision is almost always driven by data and patient specifics, and surgery is frequently the recommended standard of care for achieving the best long-term function.
The reason for this divergence lies in predictable outcomes. While some very small, inactive dogs can develop enough scar tissue to stabilize the knee without surgery, this is not the case for most. For active dogs or any dog over about 30 pounds, the odds are stacked against conservative management. In fact, research from veterinary orthopedic specialists shows a 90-95% success rate for TPLO surgery (Tibial Plateau Leveling Osteotomy) in returning dogs to near-normal function, compared to a success rate as low as 60% for conservative management, which often leads to progressive arthritis and pain.
This is a critical point where a GP’s experience may be limited. While many GPs can perform certain types of CCL repair, the more advanced and successful procedures like the TPLO are typically the domain of board-certified surgeons. A surgeon who performs dozens of these procedures a month has a level of proficiency and understanding of potential complications that a GP who performs one or two cannot match. If your GP offers to perform the surgery, it is your responsibility to vet their experience with the specific procedure they are recommending.
Here are the crucial questions to ask to determine if your GP is equipped for this surgery or if a referral to a specialist is the wiser choice:
- How many CCL surgeries of this specific type do you perform per month?
- What is your personal complication rate for this procedure (e.g., infection, implant failure)?
- Do you have specialized orthopedic equipment, or are you using a general surgical pack?
- What post-operative rehabilitation services or protocols do you have in place?
- At what point do you typically refer a challenging CCL case to a board-certified surgeon?
Asking these direct questions is not an insult; it is due diligence. For a chronic, degenerative condition like a CCL tear, choosing the right procedure with the right professional the first time is the most effective way to prevent long-term suffering and additional expense.
The Dosing Mistake That Makes Antibiotics Fail in 50% of Cases
For a pet owner trapped in the cycle of a recurring infection, the antibiotic prescription is a familiar ritual. But what if the reason the infection keeps coming back is not a failure of the drug, but a failure of the diagnostic process? One of the most common mistakes in managing recurring infections, particularly in the skin or urinary tract, is repeated treatment with broad-spectrum antibiotics without performing a culture and sensitivity (C&S) test. This is the equivalent of firing a shotgun in the dark and hoping you hit the target.
A C&S test is a simple procedure: a sample is taken from the infection site, the bacteria are grown in a lab, and then exposed to various antibiotics to see which ones are effective. This provides a “road map” for treatment, identifying the exact bacterial villain and its specific weaknesses. Without this information, the veterinarian is making an educated guess. While that guess might be right the first time, with each subsequent infection, the odds of encountering a resistant bacteria increase dramatically. This leads to treatment failure, wasted money, and the promotion of dangerous antibiotic resistance.
Furthermore, even with the right antibiotic, underdosing is a rampant problem that contributes to failure. This isn’t just about giving too low a dose per day; it’s about not treating for a long enough duration. Deep-seated or chronic infections require extended treatment courses—often 4 to 6 weeks, not the standard 10-14 days—to fully eradicate the bacteria. Ending a course of antibiotics too early is a primary driver of recurrence and resistance, as it kills off the weakest bacteria but leaves the strongest “persister” cells to repopulate.
Case Study: The Economic Value of Targeted Therapy
The principle of targeted therapy over broad-spectrum guessing has clear, measurable benefits. A 2024 study tracking 500 dogs with recurring UTIs found a stark difference in outcomes. Dogs treated with antibiotics chosen based on a veterinarian’s “best guess” required an average of 3.2 courses of antibiotics to resolve the issue. In contrast, dogs whose treatment was guided by an initial culture and sensitivity test required only 1.4 courses on average. This highlights not only the superior clinical outcome but also the significant long-term cost savings of investing in proper diagnostics upfront.
If your pet has had more than two rounds of antibiotics for the same issue without a culture being performed, it’s time to demand one. This is a hallmark of the specialist approach: stop guessing and start testing. It’s the only way to break the cycle of infection and ensure the right drug is used at the right dose for the right duration.
Timeline for Spay Recovery: What to Expect Day by Day?
Even a “routine” procedure like a spay or neuter deserves a specialist-level attention to detail, especially regarding recovery. For most owners, the post-operative instructions are simple: keep them quiet, use the e-collar, and come back in 10-14 days for suture removal. But recovery is a dynamic process with distinct physical and psychological phases. Understanding this timeline helps you provide better care, reduce your pet’s stress, and spot potential complications early.
A common pitfall is focusing only on the physical healing of the incision while ignoring the psychological impact of the surgery and confinement. Anesthesia can cause temporary confusion and dysphoria, and the subsequent forced inactivity can lead to extreme boredom and frustration, which can manifest as destructive behavior or obsessive licking of the incision. A proactive recovery plan addresses both the body and the mind.
The following table provides a more nuanced guide to what you can expect day by day, allowing you to tailor your management to your pet’s evolving needs.
| Day | Physical Recovery | Psychological State | Management Tips |
|---|---|---|---|
| Day 1 | Grogginess, minimal appetite | Confusion, dysphoria from anesthesia | Quiet, dark room; minimal stimulation |
| Days 2-3 | Incision tender, swelling peaks | Returning to normal awareness | Begin gentle interaction |
| Days 4-7 | Healing progressing, itching begins | Extreme boredom, frustration | Food puzzles, lick mats for enrichment |
| Days 8-10 | Incision closing, reduced swelling | Restlessness increasing | Short leash walks, mental games |
| Days 11-14 | Near complete healing | Energy returning to normal | Gradual return to normal activity |
The dreaded “cone of shame” is another source of significant stress. While necessary, the traditional plastic e-collar is often overkill and can make it difficult for pets to eat, drink, and navigate their environment. Fortunately, there are many effective and more comfortable alternatives. Proactively discussing these with your vet and even acclimating your pet to one *before* surgery can dramatically improve their recovery experience.
- Surgical Recovery Suits: These “onesies” for pets are excellent for cats and calm dogs, preventing licking while allowing for normal movement and vision.
- Inflatable Donut Collars: These are less cumbersome and allow for easier eating and drinking, though they may not be effective for long-snouted dogs or very flexible cats.
- Soft Fabric Cones: These are more comfortable for sleeping and less likely to cause damage to your walls and furniture.
By approaching recovery with a plan that considers both the physical and psychological needs of your pet, you are applying a specialist’s mindset to a common procedure, ensuring a smoother and less stressful experience for everyone.
Why General Vets Receive Less Than 20 Hours of Nutrition Training?
You trust your veterinarian as an authority on all aspects of your pet’s health, and for good reason. Yet, there is a significant, systemic blind spot in veterinary education that most owners are completely unaware of: clinical nutrition. The surprising truth is that the average general practitioner graduates from veterinary school with fewer than 20 hours of formal nutrition training. This is a stark contrast to the thousands of hours dedicated to surgery, pharmacology, and internal medicine.
This educational gap creates a vacuum that is often filled by pet food manufacturers. Many of the limited nutrition courses offered in vet schools are sponsored by large corporations that make prescription diets. This creates an environment where the line between education and marketing becomes blurred. As a result, many vets are most familiar with the specific diets their school’s corporate sponsor promoted, and they may not be as well-versed in alternative brands or the principles of formulating a diet from scratch.
The limited nutrition education in veterinary schools often comes from industry-sponsored programs, creating an inherent conflict between education and marketing.
– Dr. Lisa Freeman, DVM, PhD, DACVN, Journal of Veterinary Medical Education
This is not to say that prescription diets are bad; they are often life-saving. However, it does mean that when your GP recommends a specific brand, their recommendation may be based more on familiarity and brand-provided information than on a deep, comparative analysis of all available options. For a pet with a chronic condition like food allergies, IBD, or kidney disease, this is where a board-certified veterinary nutritionist (DACVN) becomes invaluable. A nutritionist operates independently of brand influence and can formulate a diet specifically tailored to your pet’s unique, complex needs—whether it’s a commercial diet or a balanced homemade recipe.
If you feel that nutrition is a key component of your pet’s chronic illness and you’re not seeing results, it’s time to probe deeper. Here are the questions you should ask your vet to assess the basis of their recommendation:
- What is the specific medical reason for recommending this diet over another brand with similar properties?
- Are there other, less expensive brands that meet the same nutritional requirements?
- Could we work with a board-certified nutritionist to formulate a homemade diet that meets these goals?
- Have you consulted with a nutritionist about my pet’s specific case?
- What peer-reviewed, independent research supports this dietary approach for my pet’s condition?
Recognizing this systemic gap in training empowers you to seek out true expertise when nutrition is on the line, ensuring your pet’s diet is a form of medicine, not just a matter of convenience.
Why “Replacement Value” Limits Damages in Vet Lawsuits?
In the devastating event that your pet is harmed or dies due to veterinary negligence, the emotional toll is immeasurable. However, when seeking legal recourse, many owners are shocked to discover a harsh legal doctrine: in most jurisdictions, pets are considered personal property. This means that financial damages in a malpractice lawsuit are often limited to the pet’s “fair market value” or “replacement value”—a negligible amount for a beloved mixed-breed rescue.
This legal framework fails to recognize the deep emotional bond between owners and their pets, a bond that is the very source of the profound grief and anger that fuels such lawsuits. The law, in its cold calculation, does not typically compensate for emotional distress, pain and suffering, or loss of companionship. This is a significant barrier to holding a negligent practitioner accountable, as the potential financial recovery often doesn’t even cover the legal fees required to pursue a case.
However, the legal landscape is slowly beginning to evolve. Courts are starting to acknowledge the unique status of companion animals as more than mere property. This shift is creating new avenues for recovering damages that better reflect the true value of a pet’s life.
Case Study: The Legal Evolution in Pet Valuation
A hopeful trend is emerging in U.S. courts. Recent cases in states like Tennessee and Alaska have begun recognizing “sentimental value” or emotional distress damages for pets, allowing courts to award compensation that goes far beyond simple market value. For instance, in a landmark 2023 decision, an Alaska court awarded a pet owner $30,000 in emotional distress damages for the suffering caused by negligent veterinary care that led to their dog’s death. These cases, while still not the norm, signal a potential shift in legal doctrine that may eventually provide a more just pathway for owners.
If you believe you have a case of veterinary malpractice, the most critical step you can take is meticulous documentation from day one. Your emotional turmoil is valid, but a successful legal case is built on a foundation of cold, hard facts. You must become the primary archivist of your pet’s medical journey, as this evidence will be the cornerstone of any future legal action.
- Keep a Detailed Journal: Document everything—dates, times, symptoms observed, medications given, and your pet’s response.
- Save All Communications: Archive every email, text message, and voicemail from the veterinary clinic.
- Request All Records: After every single visit, request a complete copy of the medical records, including all lab results and imaging studies. Do not wait until you are angry to do this.
- Document Conversations: Immediately after any phone call or consultation, write a detailed summary of who you spoke to and what was said.
- Photograph Evidence: Take daily, well-lit photos of surgical sites, injuries, or other physical symptoms to create a visual timeline.
- Track Expenses: Keep every receipt, estimate, and payment record in an organized file.
While no amount of money can replace your companion, understanding the legal realities and preparing diligently can provide a path to accountability and may help prevent a similar tragedy from happening to another family.
Key Takeaways
- Chronic issues often require a diagnostic approach that is fundamentally different from the broad scope of general practice.
- The higher upfront cost of specialist diagnostics often provides long-term economic value by preventing cycles of ineffective and costly treatments.
- Empowered owners ask specific, data-driven questions about a veterinarian’s experience, diagnostic methods, and treatment philosophy.
Kidney Failure: The Silent Symptoms Most Owners Miss Until Stage 3
Chronic kidney disease (CKD) is a perfect and tragic example of a condition where the specialist approach can radically alter an outcome. It is a silent disease. By the time most owners notice the classic signs—increased thirst, frequent urination, weight loss—the pet has often already lost a staggering 75% of its kidney function. At this point, the disease has progressed to Stage 3 or 4, and management becomes a significant, uphill battle focused on preserving the small amount of function that remains.
This is where the specialist’s toolkit and philosophy make a life-altering difference. A forward-thinking GP or a veterinary internal medicine specialist will not wait for traditional markers like creatinine to rise on a blood panel. They will utilize an advanced diagnostic test called SDMA (Symmetric Dimethylarginine). The impact of this test cannot be overstated; the International Renal Interest Society reports that SDMA testing can detect kidney disease when as little as 25% of function is lost. This early detection—months or even years before traditional tests—is the single most important factor in extending a pet’s quality and quantity of life.

Once diagnosed, a specialist manages CKD with a nuanced, multi-faceted approach guided by the IRIS staging system. This system provides a framework for escalating care as the disease progresses, moving beyond a simple “prescription diet” to include phosphorus binders, blood pressure medication, and supportive therapies like subcutaneous fluids. Understanding which stage your pet is in allows for a targeted management plan that maximizes quality of life.
| IRIS Stage | Kidney Function Remaining | Quality of Life | Management Focus |
|---|---|---|---|
| Stage 1 | 100-50% | Normal, no symptoms | Monitoring, diet modification |
| Stage 2 | 50-33% | Mild symptoms, good QOL | Prescription diet, blood pressure control |
| Stage 3 | 33-25% | Moderate symptoms appearing | Fluid therapy, phosphorus binders |
| Stage 4 | Less than 25% | Significant impact on daily life | Intensive support, quality vs quantity decisions |
If your pet is aging or belongs to a breed predisposed to kidney disease (like Maine Coons or Beagles), you should not wait for symptoms to appear. Proactively ask your vet for an annual wellness panel that includes the SDMA test. This is the epitome of shifting from reactive to proactive care. Catching CKD in Stage 1 or 2, when your pet still feels perfectly fine, is the key to giving them many more good years. It’s a choice that moves you from being a passive observer to the captain of your pet’s healthcare team.